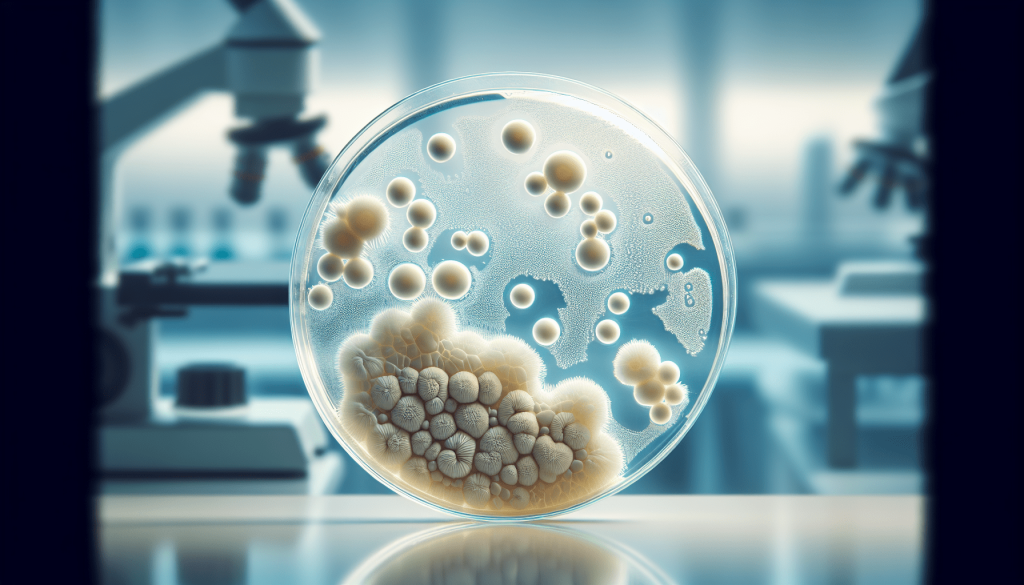
What Does a Yeast Infection Look Like?

Have you ever wondered what a yeast infection looks like? This common condition can cause discomfort and irritation – but what are the physical signs to look out for? In this article, we will explore the visual appearance of a yeast infection, helping you to recognize the symptoms and seek appropriate treatment. From characteristic swelling and redness to the presence of white, cottage cheese-like discharge, understanding how a yeast infection manifests visually can be key in addressing this pesky problem. So, let’s take a closer look at what a yeast infection looks like and how to identify it.
Symptoms of a Yeast Infection
Yeast infections can cause a variety of unpleasant symptoms that can differ depending on the affected area. If you suspect you may have a yeast infection, it’s important to be aware of the common signs and symptoms to seek appropriate treatment. Here are some symptoms that are commonly associated with yeast infections:
Itching and Irritation
One of the most common symptoms of a yeast infection is intense itching and irritation in the affected area. This can be particularly bothersome in the vaginal area, causing discomfort and a constant urge to scratch. Itching can also occur in other areas, such as the mouth in the case of oral thrush.
Burning Sensation
Yeast infections can often cause a burning sensation, especially during urination or sexual intercourse. This burning sensation can be quite uncomfortable and may be accompanied by redness and swelling in the affected area.
Redness and Swelling
Redness and swelling are common symptoms of yeast infections, particularly in the vaginal area. The skin may appear inflamed and feel tender to the touch. In some cases, redness and swelling can also occur in other areas such as the mouth or on the head of the penis.
Pain During Urination or Sex
Yeast infections can cause pain and discomfort during urination or sexual intercourse. This can be attributed to the inflammation and irritation of the affected area. It’s important to seek medical advice if you experience pain during these activities to determine the cause and receive proper treatment.
Thick, White Discharge
One of the distinguishing characteristics of a yeast infection is the presence of a thick, white discharge. This discharge may resemble cottage cheese and can have a distinct odor. It is important to note that not all cases of thick, white discharge are indicative of a yeast infection, and proper diagnosis from a healthcare professional is important.
Appearance of Yeast Infection in Different Areas of the Body
Yeast infections can occur in various areas of the body, each exhibiting different symptoms and characteristics. Here are some common types of yeast infections based on their location:
Vaginal Yeast Infection
Vaginal yeast infections are one of the most common types of yeast infections in women. External symptoms may include itching, redness, and swelling in the vulva. Internally, the vaginal walls may appear red and irritated. It is important to note that vaginal yeast infections can also be accompanied by symptoms such as pain during urination or sex.
Oral Thrush
Oral thrush is a yeast infection that affects the mouth and throat. It is characterized by the presence of white patches on the tongue and inner cheeks. These patches may be painful and can cause soreness and difficulty swallowing. In severe cases, cracking at the corners of the mouth, known as angular cheilitis, may also be present.
Yeast Infection in Men
While yeast infections are more commonly associated with women, they can also occur in men. In men, yeast infections can cause redness and itching on the head of the penis. White, clumpy discharge may also be present. Burning sensation during urination can also be a symptom of a yeast infection in men.
Yeast Infection in Babies
Babies can also be susceptible to yeast infections, particularly in the diaper area. Yeast infections in babies often present as a diaper rash, characterized by redness, inflammation, and raised bumps. In addition to diaper rash, babies with yeast infections may develop white patches in the mouth, known as thrush. Breastfeeding mothers may also experience thrush on their nipples.
Vaginal Yeast Infection
Vaginal yeast infections are a common occurrence in women, causing discomfort and distress. Understanding the symptoms associated with this type of infection is important for timely treatment. Here are the external and internal symptoms commonly associated with vaginal yeast infections:
External Symptoms
Exterior signs of a vaginal yeast infection often include itching, redness, and swelling in the vulva and surrounding areas. These symptoms may cause discomfort and irritation. It is crucial to avoid scratching the affected area, as this can lead to further inflammation and potential secondary infections.
Internal Symptoms
Internally, vaginal yeast infections may cause redness and irritation of the vaginal walls. The presence of thick, white discharge is also commonly observed. This discharge typically has a cottage cheese-like consistency and may have a distinct odor. If you experience any of these internal symptoms, it is recommended to seek medical advice for accurate diagnosis and appropriate treatment.
Potential Complications
Although vaginal yeast infections are generally not considered serious, it is important to be aware of potential complications that can arise if left untreated. Recurrent yeast infections may indicate underlying health issues that need to be addressed, and persistent symptoms can disrupt daily activities and cause significant discomfort. If you are experiencing recurrent or severe symptoms, it is advisable to consult a healthcare professional for further evaluation and management.
Oral Thrush
Oral thrush is a common type of yeast infection that can affect individuals of all ages, particularly infants, the elderly, and those with weakened immune systems. Recognizing the symptoms of oral thrush is essential for early detection and appropriate treatment. Here are some common signs and symptoms associated with oral thrush:
White Patches on the Tongue and Inner Cheeks
One of the primary indicators of oral thrush is the presence of white patches on the tongue and inner cheeks. These patches may have a curd-like appearance and can be difficult to scrape off. In some cases, the entire tongue may be covered with a white coating. These patches may cause discomfort and can sometimes bleed if scraped or irritated.
Soreness and Difficulty Swallowing
Oral thrush can cause soreness and discomfort in the mouth and throat. This can make swallowing painful and challenging, particularly when consuming solid foods or acidic substances. The soreness and discomfort can range from mild to severe, depending on the extent of the infection.
Cracking at the Corners of the Mouth
In some cases, oral thrush can lead to cracking and redness at the corners of the mouth, a condition known as angular cheilitis. These cracks can be painful, especially when opening the mouth wide or during meals. Angular cheilitis can make basic activities like eating and talking uncomfortable.
It is important to seek medical advice if you suspect you have oral thrush, as it can be an indication of an underlying health condition or a weakened immune system that needs to be addressed. Treatment options are available to alleviate symptoms and address the underlying cause.
Yeast Infection in Men
While yeast infections are commonly associated with women, men can also experience these fungal infections. Recognizing the symptoms of yeast infection in men is crucial for proper diagnosis and effective treatment. Here are some common symptoms that men may experience:
Redness and Itching on the Head of the Penis
Yeast infections in men can cause redness and itching on the head of the penis, also known as balanitis. The affected area may appear inflamed and feel sensitive to touch. Itchiness can be particularly bothersome and can cause discomfort throughout the day.
White, Clumpy Discharge
Another symptom that men may experience during a yeast infection is the presence of white, clumpy discharge under the foreskin. This discharge may have a cottage cheese-like texture and can contribute to discomfort and irritation. It is important to note that not all cases of discharge in men are indicative of a yeast infection, and a proper diagnosis should be obtained from a healthcare professional.
Burning Sensation During Urination
Yeast infections in men can also cause a burning sensation during urination. This can be quite uncomfortable and can further exacerbate the inflammation and irritation in the affected area. If you experience this symptom, it is advisable to seek medical attention for appropriate diagnosis and treatment.
Yeast Infection in Babies
Babies, especially those in diapers, are susceptible to yeast infections. These infections can cause discomfort for the baby and concern for parents. Recognizing the signs of yeast infection in babies is essential for appropriate treatment. Here are some common symptoms seen in babies with yeast infections:
Diaper Rash
Yeast infections in babies often present as a diaper rash. The affected area may appear red, inflamed, and raised. The rash can cause discomfort and may be accompanied by itching or a burning sensation for the baby. It is important to change diapers frequently and maintain good hygiene to prevent the spread of the infection.
White Patches in the Mouth
Thrush, a common type of yeast infection in babies, can manifest as white patches in the mouth. These patches typically appear on the tongue, inner cheeks, and the roof of the mouth. The patches may be difficult to remove and can cause discomfort for the baby while feeding.
Thrush in Breastfeeding Mothers
Yeast infections can also affect breastfeeding mothers, presenting as thrush on the nipples. Symptoms may include sore, itchy, or cracked nipples. The baby may also develop thrush in the mouth due to the transfer of yeast during breastfeeding. Proper treatment and hygiene measures are essential to prevent the spread of infection between mother and baby.

Diagnosing a Yeast Infection
Proper diagnosis of a yeast infection is crucial to ensure accurate treatment. Healthcare professionals may employ various methods to diagnose a yeast infection. Here are some common approaches used for diagnosis:
Medical History and Physical Examination
During a medical evaluation, your healthcare provider will begin by obtaining your medical history. This will help identify any potential risk factors or underlying conditions that may contribute to the development of a yeast infection. A physical examination will also be conducted to assess the visible symptoms and affected areas.
Sample Collection
In some cases, a sample of the discharge or affected tissue may be collected for further examination. This sample can help confirm the presence of yeast and rule out other possible causes of the symptoms. It is important to follow your healthcare provider’s instructions for sample collection to ensure accurate diagnostic results.
Laboratory Tests
Laboratory tests, such as a microscopic examination or culture, may be performed to confirm the diagnosis of a yeast infection. These tests can help identify the specific type of yeast and determine the most appropriate treatment. The results of the laboratory tests will guide your healthcare provider in providing targeted treatment options.
Preventing Yeast Infections
Taking preventative measures can help reduce the risk of developing a yeast infection. By incorporating these strategies into your daily routine, you can promote optimal vaginal and overall health. Here are some tips for preventing yeast infections:
Maintaining Good Hygiene
Practicing good hygiene is essential for preventing yeast infections. This includes regular bathing, especially after exercising or engaging in activities that cause sweating. Thoroughly dry the genital area after washing to prevent moisture buildup, as yeast thrives in warm and damp environments.
Avoiding Douching and Vaginal Sprays
Douching and using vaginal sprays disrupt the natural balance of bacteria in the vagina, making it more susceptible to yeast overgrowth. Avoid these practices to maintain a healthy vaginal environment.
Wearing Breathable Cotton Underwear
Synthetic fabrics can trap moisture and heat, providing an ideal environment for yeast to flourish. Opt for breathable cotton underwear to allow for proper airflow and reduce the risk of yeast infections.
Limiting Sugar Consumption
Yeast feeds on sugar, so it is important to limit your sugar consumption. High-sugar diets can contribute to the overgrowth of yeast in the body, increasing the risk of developing an infection. Choose a well-balanced diet that includes plenty of fruits, vegetables, and whole grains.
Taking Probiotics
Probiotics are beneficial bacteria that can help regulate the balance of microorganisms in the body. Taking probiotic supplements or consuming foods rich in probiotics, like yogurt, can promote vaginal health and reduce the risk of yeast infections.
By adopting these preventative measures, you can significantly reduce your risk of developing a yeast infection. However, it is important to note that these measures may not guarantee complete prevention and cannot replace proper medical treatment if an infection does occur.
When to See a Doctor
While yeast infections are common and generally not a cause for concern, there are certain situations where seeking medical advice is recommended. Here are some instances when you should consider consulting a healthcare professional:
Recurrent Yeast Infections
If you experience recurrent yeast infections, it is essential to consult a doctor. Recurring infections may signal an underlying condition or an imbalance in the body that needs to be addressed. Your healthcare provider can help identify potential causes and recommend appropriate treatment options.
Severe Symptoms
If your symptoms are severe, causing significant discomfort or interfering with your daily activities, it is advisable to seek medical attention. Severe symptoms may require stronger medication or alternative treatment options to alleviate your discomfort and promote healing.
Presence of Other Underlying Conditions
If you have other underlying conditions that may weaken your immune system or increase your susceptibility to infections, it is important to consult a doctor. Medical conditions such as diabetes, HIV/AIDS, or autoimmune disorders can impact the body’s ability to fight off yeast infections and may require specialized treatment.
By seeking medical advice in these situations, you can receive appropriate treatment and ensure that any underlying causes or complications are addressed effectively.
Treatment Options for Yeast Infections
Treatment options for yeast infections may vary depending on the severity and location of the infection. Here are some common treatment options that healthcare professionals may recommend:
Over-the-Counter Antifungal Creams
For mild cases of yeast infections, over-the-counter antifungal creams or ointments can be effective in clearing the infection. These topical treatments work by killing the yeast, relieving symptoms, and facilitating the healing process. It is important to follow the instructions provided and complete the full course of treatment to ensure complete eradication of the infection.
Prescription Medications
In more severe or recurrent cases, your healthcare provider may prescribe oral antifungal medications to tackle the infection from within the body. These medications are typically more potent and can effectively eliminate the yeast overgrowth. It is important to take the full prescribed course of medication, even if symptoms improve, to prevent the recurrence of the infection.
Alternative Treatments
Some individuals may opt for alternative treatments to manage yeast infections. These can include natural remedies, such as tea tree oil or yogurt, which have antifungal properties. It is essential to consult a healthcare professional before attempting alternative treatments to ensure they are safe and effective.
In conclusion, yeast infections can cause a range of uncomfortable symptoms and affect various areas of the body. Recognizing these symptoms and seeking appropriate treatment is important to alleviate discomfort and prevent complications. By practicing good hygiene, making lifestyle changes, and seeking medical advice when necessary, you can effectively manage and prevent yeast infections. Remember to consult a healthcare professional for accurate diagnosis and treatment recommendations tailored to your specific situation.